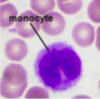
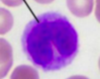
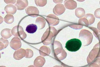
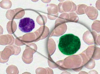
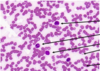
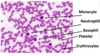

מערכת הדם Flashcards
(46 cards)
מהו ההרכב של הדם הפריפרי?
תאי דם אדומים
תאי דם לבנים (מיעוט)
פלסמה
ממה הפלסמה מורכבת?
בעיקר ממים. ניתן למצוא בתוכה גם חלבונים כמו אלבומין, גלובולין ופיברינוגן. יש בה גם אלקטרוליטים, נוטריינטים, חמצן/ פדח ותוצרי פסולת שיש לפנות מהגוף.
בקיצור- מים, חלבונים, דברים שבאים מהתאים.
איך נקראים תאי דם אדומים ומה מאפיין שלהם?
אריתרוציטים
אין להם גרעין
מה יש בתאי דם לבנים?
(“כוללים”)
טסיות, לויקוציטים, נויטרופילים, לימפוציטים, מונוציטים, אאוזונופילים, באזופילים.
מהי החלוקה באחוזים של הרכב הדם בדם הפריפרי?
לא נראה לי חובה לדעת
פלסמה- 55%
תאי דם אדומים- 44%
תאי דם לבנים- 1%
מה בסלייד?
משטח דם

אדום- תאי דם אדומים
ירוק- תאי דם לבנים
תכלס- טסיות (ממש קטנטנות בכללי וגם לעומת תאי הדם האדומים)

מה תאי דם אדומים (אריתרוציטים) מכילים ומה התפקיד שלהם?
מכילים המוגלובין בעיקר
תפקידם הוא לשאת חמצן ולנקח פדח
מה השם התקין של טסיות הדם ומה התפקיד שלהן?
טרומבוציטים
מעורבות בתהליך קרישת הדם, מגיעות ויוצרות פלאק שסותם את הדימום
קטנטנות! לעומת תאי הדם האדומים
איזה סוגים של תאי דם לבנים יש?
מה מאפיין את הגרעין (ובעצם את המראה) של כל אחד מהם?
מונוציטים- גרעין שנראה כמו כליה
נויטרופילים- אונה, 3-5 סגמנטים
לימפוציטים- גרעין אחד כהה שתופס את רוב התא
אאוזונופילים- גרעין מחולק ל2-3 אונות
בזופילים- גרעין שמחולק ל2-3 אונות
מהו המונוציט?
מה התפקיד שלו?
איך הוא נראה?
תא דם לבן
בולע ומעכל חיידקים, מציג אנטיגן על ממברנת התא עבור תאים אחרים של מערכת החיסון, מפריש ציטוקינים שמגבירים תהליך דלקתי, בסוף התהליך הדלקתי יודעים לנקות את שאריות הזיהום שנותרו ולעזור לרקמה להתרפא
הגרעין שלו כהה ונראה כמו כליה
מהו התא בתמונה?
מונוציט
מאפיין- גרעין כלייתי

מהו הנויטרופיל?
מה התפקיד שלו?
איך הוא נראה?
תא דם לבן
יודע לבלוע חיידקים ומזהמים, להפריש חומרים שהורגים גורמים זרים,התאים הלבנים הכי נפוצים בדם
גרעין אונתי, 3-5 סגמנטים

מהו הלימפוציט?
מה התפקיד שלו?
איך הוא נראה?
תא דם לבן, חלק ממערכת הלימפה גם
מהווים את תאי המערכת ההסתגלותית, ישנם תאי בי שמייצרים נוגדנים עבור תקיפת פתוגן מסוג ספציפי ותאי טי אשר פועלים גם כן נגד פתוגנים דרך מגע עם התא ולא עי הפרשת נוגדן.
גרעין אחד סגול כהה, הגודל שלהם דומה מאוד לתא דם אדום
מהו האאוזונופיל?
מה התפקיד שלו?
איך הוא נראה?
תא דם לבן,
מגיב כנגד פרזיטים, בתהליך אלרגי. נדיר למצוא במע הדם.
גרעין מחולק ל2-3 אונות, ציטופלזמה מגורגרת, יותר כהה ופחות עדינה

מהו הבזופיל?
מה התפקיד שלו?
איך הוא נראה?
תא דם לבן,
מגיב כנגד פרזיטים, בתהליך אלרגי. נדיר למצוא במע הדם.
גרעין מחולק ל2-3 אונות, הציטופלזמה באותו הצבע של הגרעין
מה מסומן בחיצים?

hematopoiesis מה זה המטופאוזיס?
השם לתהליך בו נוצרים תאי דם. מתרחש במח העצם.
איך קוראים לתהליך בו נוצרים תאי דם במח העצם?
hematopoiesis המטופואזיס
באיזה שלב של תהליך יצירת תאי הדם במח העצם ניתן לראות אותם?
hematopoiesis התהליך נקרא
כאשר הם יוצאים ממח העצם לדם הפריפרי
מה מאפיין תאי דם אדומים במח העצם בסליידים?
יהיה להם גרעין
איזה סוגים של מח עצם יש?
אדום- פעיל ומייצר תאי דם
צהוב- מנוון, המון שומן ומעט תאים שמייצרים דם
באיזה עצמות בגוף נמצא מח העצם האדום?
בגילאים צעירים- ברוב העצמות
בגילאים מבוגרים- אגן, חזה, עמוד שדרה
מה בסלייד?

עצם- ובתוכה מח עצם אדום.

מה מאפיין את רקמת מח העצם האדום?
רקמה הטרוגנית- הגוונים אינם אחידים
מגה קריוציטים- תאים גדולים עם גרעין, ייחודיים לרקמה זו (בתמונה)
סינוסואידים- אספקת דם למח העצם (וככה גם תאי הדם הבשלים מגיעים לדם הפריפרי)
























